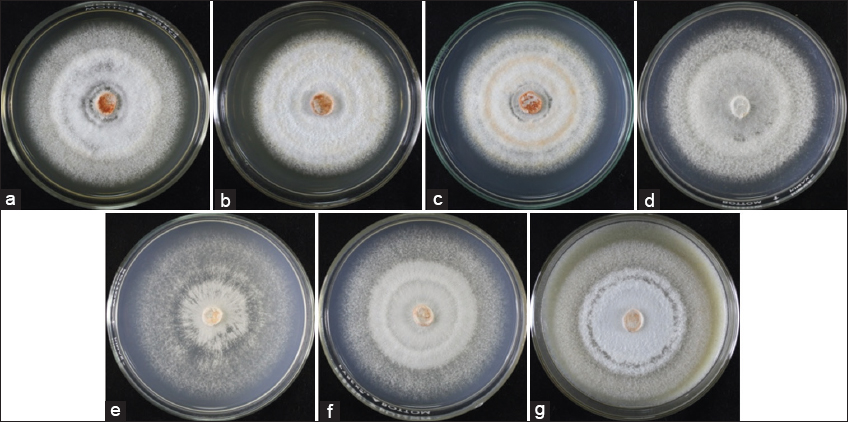

This paper reports the first work on the successful cultivation of Pycnoporus sanguineus, wild wood-rotting basidiomycetes from the Philippines. This bright red-orange, thin fan-like shaped mushroom growing on the dead hardwood was collected and was subjected to tissue culture. The mycelia favorably grew on malt extract agar (MEA) (dehydrated culture medium) and potato broth sucrose agar (indigenous culture medium) with colony diameters of 77.50 mm and 82.00 mm after 4 days of incubation, respectively. Among spawn materials used, both sorghum seeds and cracked corn recorded the short period of incubation (10 days) and very thick mycelia. The highest yield of fruiting body (17.07 g/bag) and biological efficiency (BE) (3.41%) was recorded in 8 parts rice straw + 2 parts sawdust formulation. The low BE obtained in the present work suggests optimization and enriched cultivation studies to increase the bio-efficiency.
Dulay RMR, Damaso Jr EJ. The successful cultivation of Philippine wild mushroom Pycnoporus sanguineus (BIL7137) using rice straw and sawdust-based substrate. J App Biol Biotech. 2020;8(05):72-77. DOI: https://dx.doi.org/10.7324/JABB.2020.80509
Pycnoporus sanguineus (L.) Murrill., belongs to Family Polyporaceae, is a basidiomycetous mushroom that is commonly found solitarily growing on dead hardwoods in the subtropical or tropical countries such as Philippines. Morphologically, this mushroom has bright red-orange with thin fan-like shaped sessile fruiting body with a lateral attachment to its substrate. The underside has small to medium isodiametric pores [1]. Pycnoporus is basically related with the genus Trametes, which is almost similar morphologically except to the bright red-orange fruiting body – a unique feature of genus Pycnoporus [2].
Pycnoporus species including P. sanguineus have been reported to produce highly important biologically active pigments such as cinnabarin, cinnabarinic acid, and tramesanguin, which exhibit biological activities including antioxidants, antifungal, anticarcinogenic, immunomodulatory, larvicidal, leishmanicidal activity, antiviral, antibacterial, and anti-inflammatory [3-8]. In addition, this mushroom is extensively used by native people in Australia, Brazil and Africa as natural remedy for fevers, hemorrhages, styptic, sore throats, ulcers, arthritis, gout, and tooth aches [4]. Given these findings, P. sanguineus could be an important source of bioactive metabolites and compounds with pharmacological properties.
In the Philippines, wild strains of P. sanguineus have already been documented. This mushroom is one of the macrofungal inhabitants in Angat Watershed Reservation in Norzagaray, Province of Bulacan [9], and in Aeta tribal communities in Barangay Mawacat, Pampanga and Barangay Bihawo, Zambales, Central Luzon, Philippines [10]. However, in the above-mentioned studies, the cell lines of these wild strains were not purposely rescued. Recently, a new strain was found naturally growing on dead hardwood in Lingap Kalikasan Park, Central Luzon State University (CLSU) campus in Central Luzon, Philippines and was successfully tissue cultured in the laboratory.
In our objective to explore the advantages of the Philippine wild mushrooms for their proper utilization, we demonstrated herein the successful cultivation of the rescued secondary mycelia of wild strain P. sanguineus. The performance of mycelial growth on the different culture media and the production of fruiting body on the different substrate formulations of rice straw and sawdust in fruiting bags under tropical growing house condition were evaluated. The development of fruiting body was also documented. The developed production technique is very useful in the mass cultivation of mushroom biomass for extraction and bioactivity profiling of this Philippine wild mushroom.
Wild P. sanguineus fruiting bodies [Figure 1] were collected from Lingap Kalikasan Park, CLSU, Science City of Muñoz, Nueva Ecija, Central Luzon, Philippines. The collected fruiting bodies were immediately brought in the laboratory for tissue culture.
 | Figure 1: Wild fruiting bodies of Pycnoporus sanguineus growing on dead hardwood. [Click here to view] |
A flame-sterile surgical blade was used to obtain small internal tissues of P. sanguineus and subsequently inoculated onto plated potato dextrose agar (PDA). Inoculated plates were sealed with parafilm and incubated at 30°C for 7 days. Successful cultures were coded as BIL7137 and served as source of mycelial disk inoculant in the growth performance assays.
The mycelial growth of P. sanguineus on the two groups of culture media, the dehydrated commercially-available culture media, and indigenous culture media was evaluated. Dehydrated culture media such as malt extract agar (MEA), potato dextrose agar (PDA), and Sabouraud dextrose agar (SDA) were prepared according to manufacturers’ instructions found in the label. However, the preparations of the four indigenous culture media including coconut water agar (CWA), rice bran broth agar (RBBA), corn grit broth agar (CGBA), and potato broth sucrose agar (PBSA) were similar as the described media formulation of Dulay and Garcia [11]. All culture media were sterilized at 121°C, 15 psi for 30 min in an autoclave before pour-plating. A 10 mm-diameter mycelia disk was inoculated centrally onto each plated medium and then incubated at 30°C. Triplicate test was done each treatment. The diameter of growth and the mycelial density were determined.
Cracked corn, sorghum seeds, and rice seeds were evaluated as spawn substrate. Substrates were boiled separately until tender and swollen. A 60 g of each boiled grain at 65% moisture content was dispensed into a transparent glass culture bottle with cotton plug. Three culture bottles were prepared for each grain. Substrates were sterilized at 121°C, 15 psi for 45 min. Culture bottles were inoculated with 10 mm-diameter mycelial disks and incubated at 30°C. Spawn substrate with the shortest incubation period and with very thick mycelia density was recorded and was considered as the best spawn substrate.
For the evaluation of the performance of fruiting body of P. sanguineus, rice straw and sawdust based substrate formulations were prepared following the procedure of Dulay et al. [12]. Formulated substrates (500 g) were compacted in a 6 × 12-inch polypropylene bag. Five replicates were done each formulation. Substrates were sterilized at 121°C, 15 psi for 1 h. Forty grams of best grain spawn were inoculated into each sterilized fruiting bag, and incubated at 30°C. The number of days of full mycelial colonization was recorded. Mature mycelia were exposed by opening the fruiting bags and watered 3 times a day to allow the initiation of primordia and eventually the development of fruiting bodies. The different developmental stages from mycelia coat formation to maturation of fruiting body were documented. Fruiting bodies were harvested and the yield was recorded. Percentage biological efficiency (BE) of P. sanguineus was computed using the equation, BE (%) = (total weight of fruiting bodies / total weight of the substrate) × 100.
Complete randomized design was used to lay-out all the treatments. The analysis of variance and Tukey’s honestly significant difference (HSD) at 5% level of significance in the SAS System Version 9.0 program were used to analyze and compare the data.
Cell lines of wild P. sanguineus were successfully rescued through tissue culture technique on potato dextrose agar. The secondary mycelia were cottony, radial white-orange aggressively ramifying mycelia. Some pure cultures were used in the growth evaluation while the others were maintained as stock cultures and included in our mushroom culture collections.
For the mushroom mycelia to grow, they require substrate or culture media as their nutrients source [13]. Hence, the identification of the most suitable culture media is very vital to acquire the maximum mycelial growth leading toward the generation of successful production technology. In the present study, we determined one best medium from each group of culture media. A group of dehydrated commercially-available culture media was evaluated in our intention to identify the best medium for stock culture and/or any other laboratory purposes. However, for practical and economic reasons, culture media using indigenous sources were also formulated and evaluated to determine the best medium that can be utilized by mushroom growers and farmers, which is inexpensive and locally-available. The growth diameter and density of P. sanguineus mycelia on the three dehydrated culture media and four indigenous culture media are presented in Table 1. Among the first group of media, MEA showed the fastest growth of mycelia with 77.50 mm diameter after 4 days of incubation. PDA showed the slowest mycelial growth. Tukey’s HSD revealed a significant difference of the three culture media. In terms of mycelial density, very thick mycelial growth was observed [Figure 2].
Table 1: Mycelial growth diameter of Pycnoporus sanguineus on the different culture media under different length of incubation and its mycelia density.
| Culture media | Diameter of mycelial growth (mm) | Mycelial density | ||
|---|---|---|---|---|
| Day 2 | Day 3 | Day 4 | ||
| Malt extract agar | 37.50±1.32a | 56.83±0.76a | 77.50±0.00a | ++++ |
| Potato dextrose agar | 36.67±1.53a | 50.83±0.76b | 67.67±1.04c | ++++ |
| Sabouraud dextrose agar | 33.50±1.32b | 51.00±2.18b | 72.17±2.47b | ++++ |
| Coconut water agar | 38.50±0.50a | 57.17±1.44a | 74.83±1.61c | +++ |
| Corn grit broth agar | 36.50±0.87b | 56.17±1.15b | 79.50±1.00b | ++ |
| Potato broth sucrose agar | 36.67±1.26b | 58.17±1.15a | 82.00±1.00a | +++ |
| Rice bran broth agar | 35.67±1.04b | 53.50±0.50c | 73.17±0.29c | +++ |
Values are mean±SD of three replicates. Means having the same letter of superscript in the same column are not significantly different from each other at 5% level of significance. In a column mycelial density: very thin (+), thin (++), thick (+++), very thick (++++).
| Figure 2: Mycelial growth performance of Pycnoporus sanguineus on the different culture media: (a) Malt extract agar (b) potato dextrose agar; (c) Sabouraud dextrose agar; (d) coconut water agar; (e) corn grit broth agar; (f) potato broth sucrose agar and (g) rice bran broth agar after 4 days of incubation. [Click here to view] |
Surprisingly, indigenous medium, PBSA registered the fastest growth of mycelia with 82.00 mm diameter, followed by CGBA with 79.50 mm diameter. Both CWA and RBBA showed the slowest mycelial growth. However, in mycelial density, all indigenous media, except CGBA, produced thick mycelia growth [Figure 2]. Noticeably, P. sanguineus mycelia showed varied response when grown on PDA and PBSA, which both contain potato as main ingredient. Looking at their composition, PDA has 4 g of potato extract, which is equivalent to 20% potato [14], dextrose and agar, whereas PBSA is made up of broth or decoction of 25% potato, sucrose, and agar. The better mycelial performance in PBSA could be due to the components and their concentrations, and preparation of this medium, which are suitable for the efficient growth of P. sanguineus mycelia. In the evaluation of nutritional requirements, particularly the excellent carbon source for different mushrooms, Dulay et al. [15] reported that sucrose, starch, and fructose were identified as the most favorable for the growth of Lentinus tigrinus, Lentinus swartzii, and Lentinus strigosus mycelia, respectively. Moreover, mycelial growth of both strains of Cordyceps militaris (C738 and NG3) favored sucrose as carbon source [16,17]. However, better mycelial growth was observed in disaccharides than in monosaccharides [18]. The concentration or amount of nutrients in the medium is also an important factor that affects the growth of mushroom mycelia. Dulay et al. [15] established the optimum ratio of carbon and nitrogen for efficient growth of mycelial of the three Lentinus species, and they also observed that carbon source at the lower and higher concentrations in carbon/nitrogen ratio showed suppressed the growth of mycelia of L. strigosus and L. swartzii. In the present study, the luxuriant mycelial growth on PBSA implies that P. sanguineus has greater preference for sucrose than dextrose.
The favorable mycelial growth performance on MEA and PBSA was also observed in other mushrooms. For instance, Dulay and Damaso [19] reported that PBSA and MEA showed the maximum mycelial growth of Oudemansiella canarii. In addition, MEA was identified as a suitable source of nutrients for the cultivation of Polyporus grammocephalus [20], Pleurotus ostreatus var. sajor-caju, cystidiosus, and Volvariella volvacea [21]. Moreover, PBSA favored the rapid and luxuriant growth of Coprinopsis cinerea Sto. Domingo strain, V. volvacea Rang-ayan and CLSU strains and L. strigosus [11,22].
Grain spawn, a nutritious carrier of mycelia, serves as inoculant in the production of mushroom fruiting body. In this study, three types of grains were evaluated as spawn substrate for P. sanguineus. Table 2 shows the number of days of incubation and mycelial density of P. sanguineus on the three spawn substrates. Noticeably, cracked corn recorded the shortest period of incubation of 10.00 days, followed by the sorghum seeds (10.67 days). Tukey’s HSD revealed that the difference of the two spawn substrates was insignificant. Both spawn substrates produced very thick mycelia [Figure 3]. This favorable mycelial response of P. sanguineus in cracked corn is analogous with the mycelial response of L. tigrinus and L. strigosus [12,23]. The high moisture-holding capacity, larger surface area (which allows aeration), and exposed nutritious part of cracked corn make it more advantageous than the other two spawn substrates. However, sorghum was found to be the best granular material for Pleurotus sajor-caju, Pleurotus djamor, Pleurotus columbines, and Pleurotus flabellatus [24-28]. In addition, earlier spawn development of Cantharellus spp., Pleurotus sajor-caju, and Pleurotus spp. was observed in sorghum [29-32].
Table 2: Incubation period and mycelia density of Pycnoporus sanguineus in the three spawn substrates.
| Grain spawn | Incubation period (day) | Mycelial density |
|---|---|---|
| Cracked corn | 10.00±0.00a | ++++ |
| Rice seeds | 14.33±0.58b | + |
| Sorghum seeds | 10.67±0.58a | ++++ |
Values are mean±SD of three replicates. Means having the same letter of superscript in the same column are not significantly different from each other at 5% level of significance. In a column mycelial density: very thin (+), thin (++), thick (+++), very thick (++++).
 | Figure 3: Mycelial growth of Pycnoporus sanguineus on different spawning materials: (a) cracked corn, (b) rice seeds, and (c) sorghum seeds after 10 days of incubation. [Click here to view] |
On the contrary, rice seeds registered the most extensive period of incubation of 14.33 days. Mycelia growth was noted very thin after 10 days of incubation, but turned to very thick after 2 days from the time of full mycelial colonization. This mycelial performance in rice seeds was also observed by Dulay and Rivera [20] in the evaluation of suitable spawn substrate for P. grammocephalus. They accounted this observation to the thick husk of rice seeds, which hinders the penetration of mycelia in the integral part of the rice. The results of the current work suggest that the three grains could be used as spawn substrate for P. sanguineus; however, the most suitable was cracked corn. A total of 30 bags of 40 g-cracked corn spawns were produced and used as inoculants in the production of fruiting body evaluation.
The cultivation potential of P. sanguineus was determined using rice straw and sawdust-based formulated substrates. Cracked corn spawn was inoculated in the substrate bags and incubated to allow mycelial colonization. Among different substrate formulations, 6 parts of rice straw + 4 parts of sawdust recorded the shortest incubation period of 20 days [Table 3]. However, pure sawdust showed the most extensive period of incubation (27 days). After the full mycelial ramification, fruiting bags were opened and watered to allow emergence of fruiting body. The process of fruiting body development of P. sanguineus was documented and it is shown in Figure 4. After 5 days from the time of opening and 3 times a day exposure to water, the white thin mycelia turned into red-orange thick mycelia with powder-like structures. From these powder-like thick mycelia, a pinkish to light orange mass called primordium was formed. Each primordium continually developed into antler-like young fruiting body, then expanded until a distinct pileus appeared and then matured.
Table 3: Incubation period, yield, and percentage biological efficiency of Pycnoporus sanguineus grown in the different formulations of rice straw and sawdust-based substrate
| Substrates rice straw:sawdust | Incubation period (day) | Total yield (g) | Biological efficiency (%) |
|---|---|---|---|
| 10:0 | 24.67±0.58b | 13.57±0.85b | 2.71 |
| 8:2 | 22.33±0.58c | 17.07±0.70a | 3.41 |
| 6:4 | 20.00±0.00d | 16.43±1.03a | 3.29 |
| 4:6 | 22.00±1.00c | 15.73±0.70a | 3.15 |
| 2:8 | 23.33±1.53b | 12.63±1.14b | 2.53 |
| 0:10 | 27.00±1.00a | 9.47±0.91c | 1.89 |
Values are mean±SD of three replicates. Means having the same letter of superscript in the same column are not significantly different from each other at 5% level of significance.
 | Figure 4: The fruiting body development of Pycnoporus sanguineus. [Click here to view] |
To determine the effects of different formulated substrates on the fruiting body production of P. sanguineus, the total yield and BE were determined [Table 3]. Substrate formulation of 8:2 parts of rice straw:sawdust produced the highest total yield of 17.07 g/bag with corresponding biological efficiency of 3.41%. The analysis of variance revealed that this formulation is not significantly different to 6:4 and 4:6 substrate formulations. Contrastingly, pure sawdust recorded the lowest yield. Obviously, the biological efficiencies of P. sanguineus obtained in this study are far lower when compared to commercially-cultivated mushrooms. Yang et al. [33] obtained a bio-efficiency of 125.6% for P. ostreatus when cultivated in cotton seed hull and wheat straw. Agrocybe cylindracea grown in wheat straw and soybean flour had a bio-efficiency of 179% [34]. Moreover, substrate formulation of 60% Panicum repens stalks + 30% sawdust recorded the highest bio-efficiency of 148.12% for Auricularia polytricha [35].
The previous works reported the improved biological efficiencies of some wild strains of the Philippine mushrooms through enriched cultivation and/or substrate supplementation. For instance, Dulay and Garcia [11] attained the highest BEs of 32.79% and 32.18% for wild strain L. strigosus in 20% rice bran- and 20% corn grit-supplemented rice straw, respectively. Enriched cultivation of wild strain Lentinus squarrosulus using rice straw and sawdust with 15% rice bran recorded the highest biological efficiency of 18% [36]. Moreover, rice straw supplemented with 5% and 20% rice bran produced the highest yield and BEs of 9.03% and 15.20% for Ganoderma lucidum and Schizophyllum commune, respectively [37]. According to the above-cited studies, rice bran is a very good supplement material to enrich the basal substrate for the improved bio-efficiency of wild mushrooms. In the production of Pleurotus and Agaricus, the frequently used supplements include soybean meal and other organic protein sources, among them cereal bran, enriched with minerals, or vitamins [38,39]. Moreover, Jafarpour et al. [40] reported that local agricultural materials such as sugar beet pellet pulp, boll, wood chips, palm fiber + rice bran, soya cake powder, wheat bran, and carrot pulp + rice bran have been used as substrate additives for the cultivation of oyster mushroom. Therefore, there is a need to optimize the cultural conditions and evaluate the production using enriched substrates to improve the cultivation efficiency of P. sanguineus. Although we obtained a very low bio-efficiency, to the best of our knowledge, this is the first work that demonstrated the successful cultivation of fruiting body of P. sanguineus.
This work has shown the successful cultivation of P. sanguineus mycelia on the two groups of solid culture media and fruiting body in rice straw-sawdust formulations. Malt extract agar and potato broth sucrose agar were the most favorable culture media, whereas cracked corn was the best spawn substrate. The 8:2 rice straw:sawdust formulation recorded the highest yield and biological efficiency. However, the obtained biological efficiencies in this study are very low when compared to the other wild and commercially-cultivated mushrooms, thereby suggesting further optimization studies and enriched cultivation evaluation to improve the fruiting body production and biological efficiency.
We declare that we have no conflicts of interest.
None.
1. Téllez-Téllez M, Villegas E, Rodriguez A, Acosta-Urdapilleta ML, O'Donovan A, Diaz-Godinez G. Mycosphere essay 11: Fungi of Pycnoporus: Morphological and molecular identification, worldwide distribution and biotechnological potential. Mycosphere 2016;7:1500-25. [CrossRef]
2. Ryvarden L, Gilbertson RL. European Polypores: Part 2: Meripilus-Tyromyces. Oslo, Norway: Fungiflora A/S; 1994. p. 394-743.
3. Borderes J, Costa A, Guedes A, Tavares LB. Antioxidant activity of the extracts from Pycnoporus sanguineus mycelium. Braz Arch Biol Technol 2011;54:1167-74. [CrossRef]
4. Smânia A, Monache FD, Smânia EF, Gil ML, Benchetrit LC, Cruz FS. Antibacterial activity of a substance produced by the fungus Pycnoporus sanguineus (Fr.) Murr. J Ethnopharmacol 1995;45:177-81. [CrossRef]
5. Smânia A, Marques CJ, Smânia EF, Zanetti CR, Carobrez SG, Tramonte R, Loguercio-Leite C. Toxicity and antiviral activity of cinnabarin obtained from Pycnoporus sanguineus (Fr.) Murr. Phytother Res 2003;17:1069-72. [CrossRef]
6. Bücker A, Bücker NC, Souza AQ, Gama AM, Rodrigues-Filho E, Costa FM, et al. Larvicidal effects of endophytic and basidiomycete fungus extracts on Aedes and Anopheles larvae (Diptera, Culicidae). Rev Soc Bras Med Trop 2013;46:411-9. [CrossRef]
7. Correa E, Cardona D, Quiñones W, Torres F, Franco AE, Vélez ID, et al. Leishmanicidal activity of Pycnoporus sanguineus. Phytother Res 2006;20:497-9. [CrossRef]
8. Lu MK, Lin HO, Hsu FL, Lin YL. Anti-inflammatory principles of cultivated Pycnoporus sanguineus. J Chin Med 2010;21:75-83.
9. Liwanag JM, Dulay RM, Santos EE, Flores FR, Clemente RF. Species listing of macrofungi in Angat Watershed Reservation, Bulacan Province, Luzon Island, Philippines. Int J Biol Pharm Allied Sci 2017;6:1060-8.
10. De Leon AM, Luangsa-Ard JJ, Karunarathna SC, Hyde KD, Reyes RG, Dela-Cruz TE. Species listing, distribution, and molecular identification of macrofungi in six Aeta tribal communities in Central Luzon, Philippines. Mycosphere 2013;4:478-94. [CrossRef]
11. Dulay RM, Garcia EJ. Optimization and enriched cultivation of Philippine (CLSU) strain of Lentinus strigosus (BIL1324). Biocatal Agric Biotechnol 2017;12:323-8. [CrossRef]
12. Dulay RM, Rivera AG, Garcia EJ. Mycelial growth and basidiocarp production of wild hairy sawgill Lentinus strigosus, a new record of naturally occurring mushroom in the Philippines. Biocatal Agric Biotechnol 2017;10:242-6. [CrossRef]
13. Ahmad I, Fuad I, Khan ZK. Mycelia growth of pink oyster (Pleurotus djamour) mushroom in different culture media and environmental factors. Agric and Food Sci Res 2015;2:6-11.
14. Aryal S. Potato Dextrose Agar (PDA)-Principle, Uses, Composition, Procedure and Colony Characteristics; 2015. Available from: https://www.microbiologyinfo.com. [Last accessed on 2020 Mar 17].
15. Dulay RM, Cabrera EC, Kalaw SP, Reyes RG, Hou CT. Nutritional requirements for mycelial growth of three Lentinus species from the Philippines. Biocatal Agric Biotechnol 2020;23:101506. [CrossRef]
16. Kim SW, Hwang HJ, Xu CP, Sung JM, Choi JW, Yun JW. Optimization of submerged culture process for the production of mycelial biomass and exo-polysaccharides by Cordyceps militaris C738. J Appl Microbiol 2003;94:120-6. [CrossRef]
17. Xu CP, Kim SW, Hwang HJ, Yun JW. Application of statistically based experimental designs for the optimization of exo-polysaccharide production by Cordyceps militaris NG3. Biotechnol Appl Biochem 2002;36:127-31. [CrossRef]
18. Dong CH, Yao YJ. Nutritional requirements of mycelial growth of Cordyceps sinensis in submerged culture. J Appl Microbiol 2005;99:483-92. [CrossRef]
19. Dulay RM, Damaso EJ Jr. The first report on the successful rescue and domestication of Philippine wild mushroom Oudemansiella canarii (BIL 9137). Int J Biol Pharm Allied Sci 2017;6:2359-69.
20. Dulay RM, Rivera AG. Mycelial growth and fruiting body production of Philippine (CLSU) strain of Polyporus grammocephalus (BIL7749). Biocatal Agric Biotechnol 2017;11:161-5. [CrossRef]
21. Nasim G, Malik SH, Bajwa R, Afzal M, Mian SW. Effect of three different culture media on mycelial growth of oyster and Chinese mushrooms. J Biol Sci 2001;1:1130-3. [CrossRef]
22. Kalaw SP, Alfonso DO, Dulay RM, De Leon AM, Undan JQ, Undan JR, et al. Optimization of culture conditions for secondary mycelial growth of wild macrofungi from selected areas in Central Luzon, Philippines. Curr Res Environ Appl Mycol 2016;6:277-87. [CrossRef]
23. Dulay RM, Kalaw SP, Reyes RG, Cabrera EC, Alfonso NF. Optimization of culture conditions for mycelial growth and basidiocarp production of Lentinus tigrinus (Bull.) Fr., a new record of domesticated wild edible mushroom in the Philippines. Philipp Agric Sci 2012;95:278-85.
24. Rathaiah Y, Surargiary M. Use of parboiling paddy as spawn substrate for oyster mushroom. Mushroom Res 1994;1:1-3.
25. Mathew AV, Mathai G, Suharban M. Performance evaluation of five species of Pleurotus (oyster mushroom) in Kerala. Mushroom Res 1996;5:9-12.
26. Chaurasia VK. Studies on Production Technology of Pleurotus columbines, M.Sc. (Agriculture) Thesis. Chhattisgarh: Indira Gandhi Agricultural University Raipur; 1997. p. 95.
27. Sahu SK, Singh DP, Patel R, Awadhiya GK, Vishwavidhyalaya IG. Screening of suitable grains substrates for spawn development, growth and yield of Pleurotus eous. Am Int J Res Form Appl Nat Sci 2014;5:86-9.
28. Pandey N, Kerketta A, Sahu B, Singh HK. Screening of suitable grains substrates for spawn development, growth and yield of Pleurotus flabellatu. Res J Agric Sci 2017;8:536-41.
29. Khatri RK. Studies on Mushroom Flora of Madhya Pradesh and Chhattisgarh with Special Reference to Wild Edible Bamboo Mushroom (Cantharellus spp.) Doctoral Dissertation. Raipur: Indira Gandhi Krishi Vishwavidyalaya; 2002.
30. Asghar R, Tariq M, Rehman T. Propagation of Pleurotus sajor-caju (oyster mushroom) through tissue culture. Pak J Bot 2007;39:1383-6.
31. Awasthi SK, Pande N. Spawn making and effect of spawn made-up on various substrates on yield of Pleurotus sajor-caju (Fr.) Sing, and edible mushroom. Natl Acad Sci Lett 1994;12:271-3.
32. Sagir A, Yildiz A. Growth of mycelium of Pleurotus spp. On different grains and determination of their competition with some contaminant fungi. Acta Aliment 2004;33:249-57. [CrossRef]
33. Yang WJ, Guo FL, Wan ZJ. Yield and size of oyster mushroom grown on rice/wheat straw basal substrate supplemented with cotton seed hull. Saudi J Biol Sci 2013;20:333-8. [CrossRef]
34. Uhart M, Piscera JM, Alberto E. Utilization of new naturally occurring strains and supplementation to improve the biological efficiency of the edible mushroom Agrocybe cylindracea. J Ind Microbiol Biotechnol 2008;35:595-602. [CrossRef]
35. Liang CH, Wu CY, Lu PL, Kuo YC, Liang ZC. Biological efficiency and nutritional value of the culinary-medicinal mushroom Auricularia cultivated on a sawdust basal substrate supplement with different proportions of grass plants. Saudi J Biol Sci 2019;26:263-9. [CrossRef]
36. De Leon AM, Guinto LJ, De Ramos PD, Kalaw SP. Enriched cultivation of Lentinus squarrosulus (Mont.) singer: A newly domesticated wild edible mushroom in the Philippines. Mycosphere 2017;8:615-29. [CrossRef]
37. Kalaw SP, Nabor R, Dulay RM, Undan JR, Undan JQ, De Leon AM, Reyes RG. Mycelia and fruiting body performance of Philippine wild strains of Ganoderma lucidum and Schizophyllum commune on rice bran enriched rice straw based substrates. Int J Biol Pharm Allied Sci 2017;6:1210-9.
38. Burton K, Noble R, Rogers S, Wilson J. Understanding Mushroom Nutrition: Project Aimed at Improving Yield, Substrate Efficiency and Utilisation and Flavor, M056 Final Report. United Kingdom: Agriculture and Horticulture Development Board; 2015. p. 54.
39. Zied DC, Savoie JM, PardoGiménez A. Soybean the main nitrogen source in cultivation substrates of edible and medicinal mushrooms. In: ElShemy HA, editor. Soybean and Nutrition. Rijeka: In Tech Open Access; 2011. p. 433-52.
40. Jafarpour M, Zand AJ, Dehdashtizadeh B, Eghbalsaied S. Evaluation of agricultural wastes and food supplements usage on growth characteristics of Pleurotus ostreatus. Afr J Agric Res 2010;5:3291-6.
| ||||||||||||||||||||||||||||||||||||||||||||||||||||||||||||||||||||||||||||||||||||||||||||||||||||||||||||||||||||||||||||||||||||||||||||||||||||||||||||||||||
Year
Month